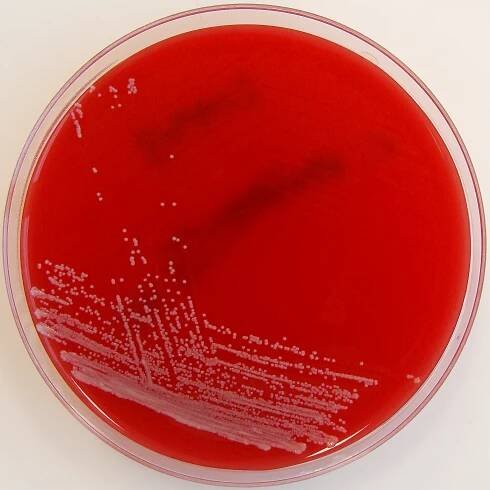

Corynebacterium
Bakterie

Corynebacterium (korynebakterie) je rod grampozitivních tyčinkovitých bakterií z kmene Actinobacteria. Je to heterogenní skupina asi 60 druhů s poměrně typickou stavbou buněčné stěny. Jsou to aerobové či fakultativní anaerobové, nepohyblivé, a kataláza-pozitivní bakterie. Mnohé korynebakterie žijí na rostlinách a v tělech živočichů, například na kůži, v dýchací… Wikipedia
Lidé také hledají
Corynebacterium – Wikipedie
Corynebacterium (korynebakterie) je rod grampozitivních tyčinkovitých bakterií z kmene Actinobacteria. Je to heterogenní skupina asi 60 druhů s poměrně typickou stavbou buněčné stěny.
Corynebacterium - Wikipedia
Corynebacterium (/ k ɔː ˈ r aɪ n ə b æ k ˌ t ɪər i ə m, - ˈ r ɪ n-/) is a genus of Gram-positive bacteria and most are aerobic.
Corynebacterium diphtheriae – Wikipedie
Corynebacterium diphtheriae je grampozitivní nepohyblivá fakultativně anaerobní bakterie bez pouzdra. Způsobuje onemocnění zvané záškrt, které se přenáší vzduchem.
Kategorie:Corynebacteriaceae – Wikipedie
Zobrazují se 2 stránky z celkového počtu 2 stránek v této kategorii.
Corynebacterium – WikiSkripta
Internetové studijní materiály pro studenty českých a slovenských lékařských fakult.
Corynebacterium diphtheriae – WikiSkripta
Internetové studijní materiály pro studenty českých a slovenských lékařských fakult.
Více než 280 stock fotografií, snímků a obrázků bez autorských…
Vyhledávejte z Corynebacterium stock fotek, snímků a obrázků bez autorských poplatků od služby iStock. Vyhledejte zde vysoce kvalitní stock fotky, které jinde nenajdete.
Charakteristika Corynebacterium pseudotuberculosis, taxonomie…
Corynebacterium pseudotuberculosis je bakterie řádu Actinomycetales. Je to bacil, který má v plodinách tvar paličky nebo klubu, nemá kapsli ani bičík. Fermenty maltóza a galaktóza, nikoli však laktóza.
Corynebacterium | Medicína, nemoci, studium na 1. LF UK
Corynebacterium (korynebakterium) je označení pro skupinu grampozitivních bakterií tyčinkovitého tvaru. Některé bakterie z této skupiny mohou tvořit toxiny a způsobit u člověka infekční onemocnění (např.
Corynebacterium durum a možnosti jeho identifikace | proLékaře…
Corynebacterium (C.) durum je součástí rezidentní flóry dutiny ústní. Jeho podíl na etiologii infekčních onemocnění je nejednoznačný.
odkazuje na služby nejen od Seznam.cz.
© 1996–2025 Seznam.cz, a.s.